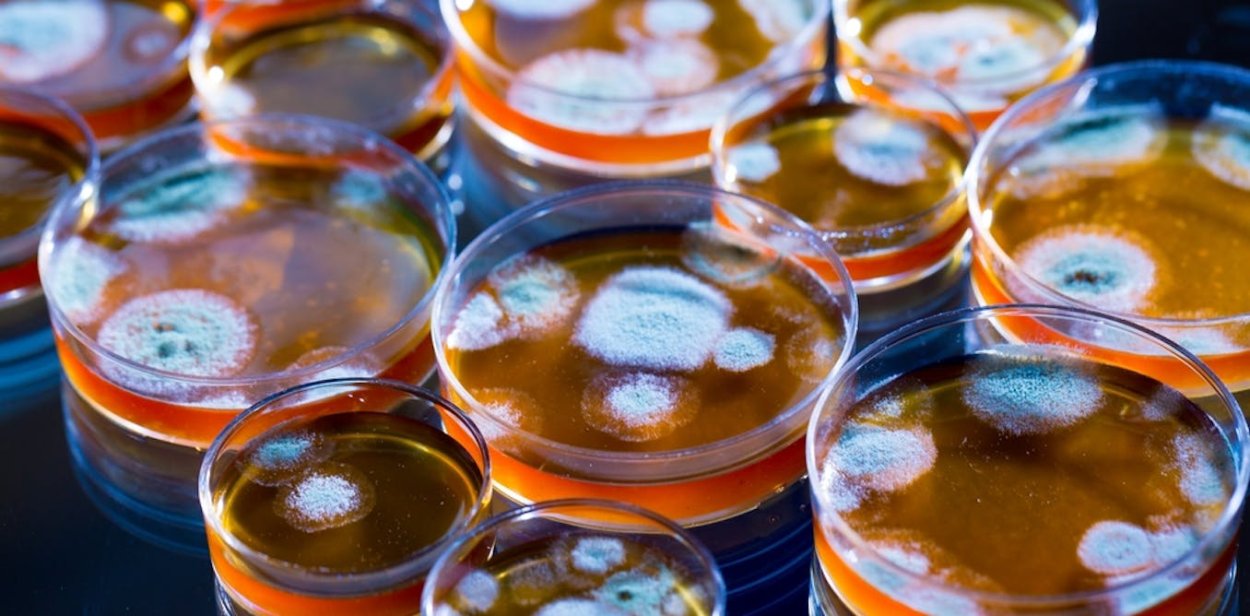
Зеленая плесень пеницилл
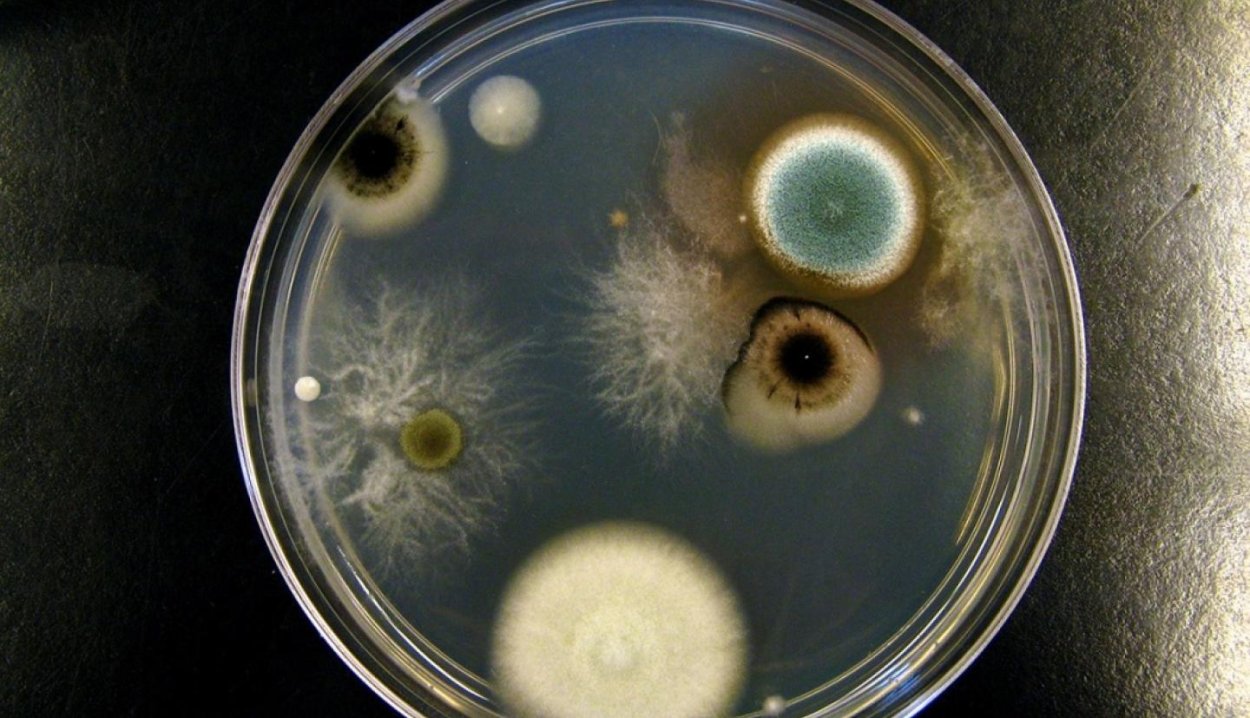
Пеницилл в чашке Петри
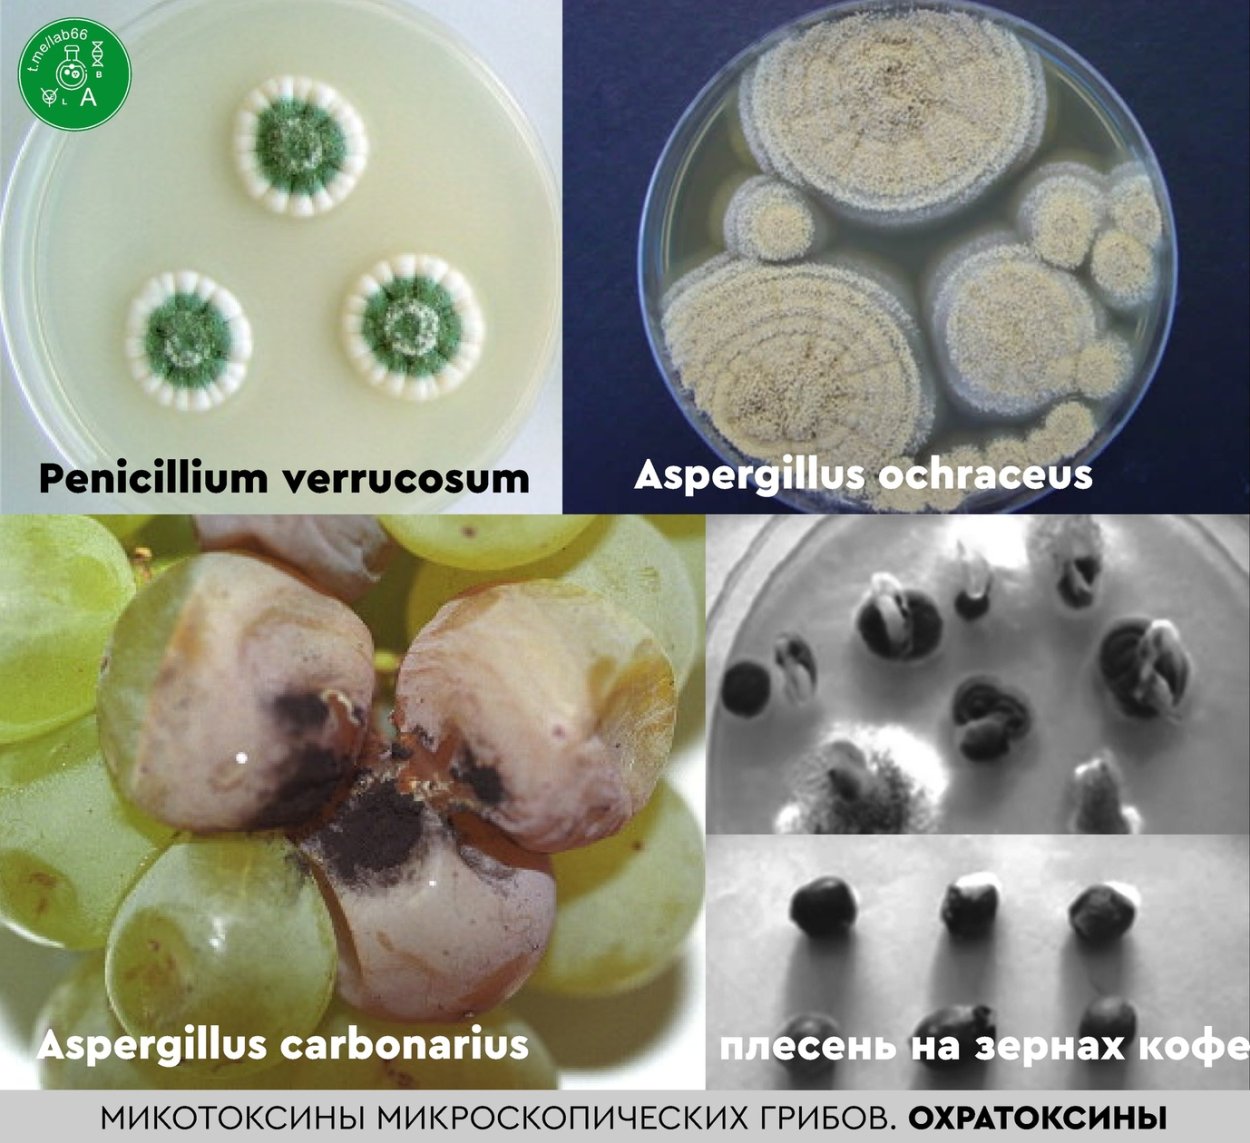
Микотоксины плесени
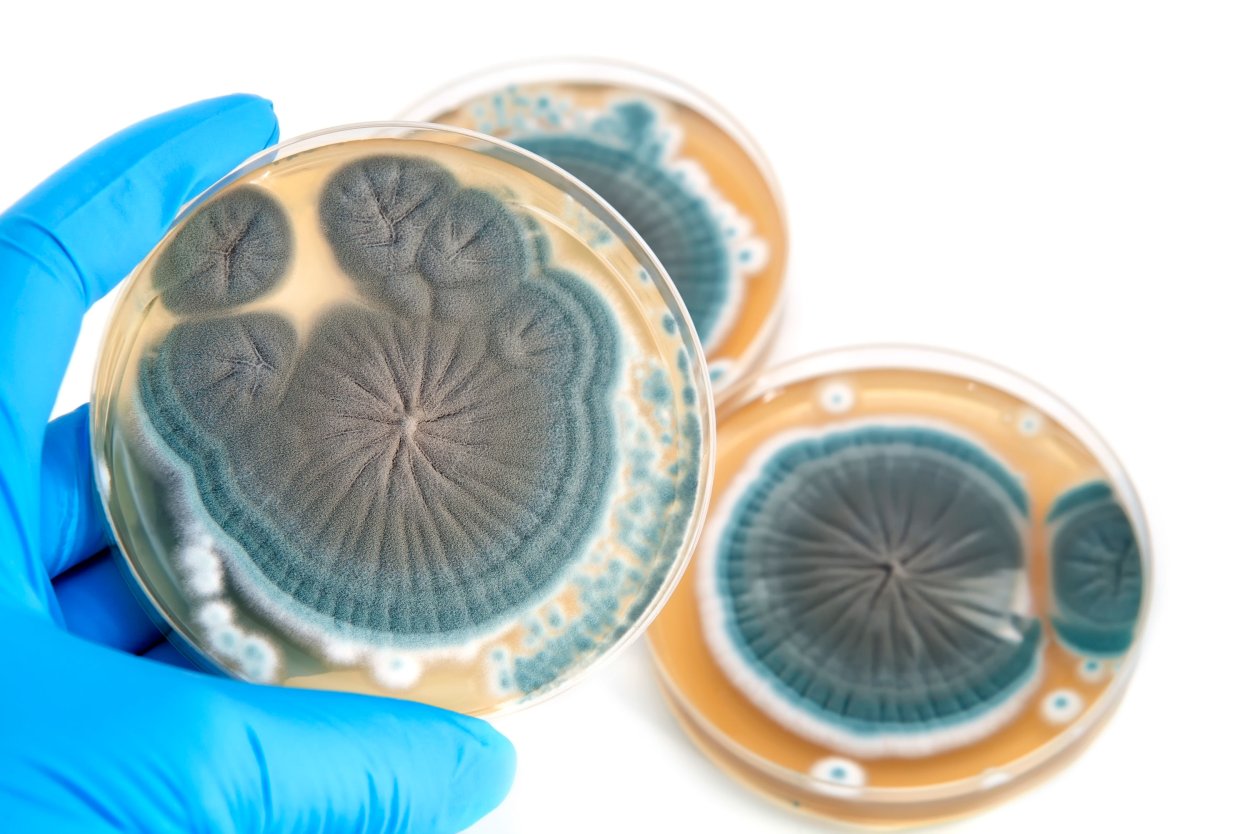
Пенициллин из плесени
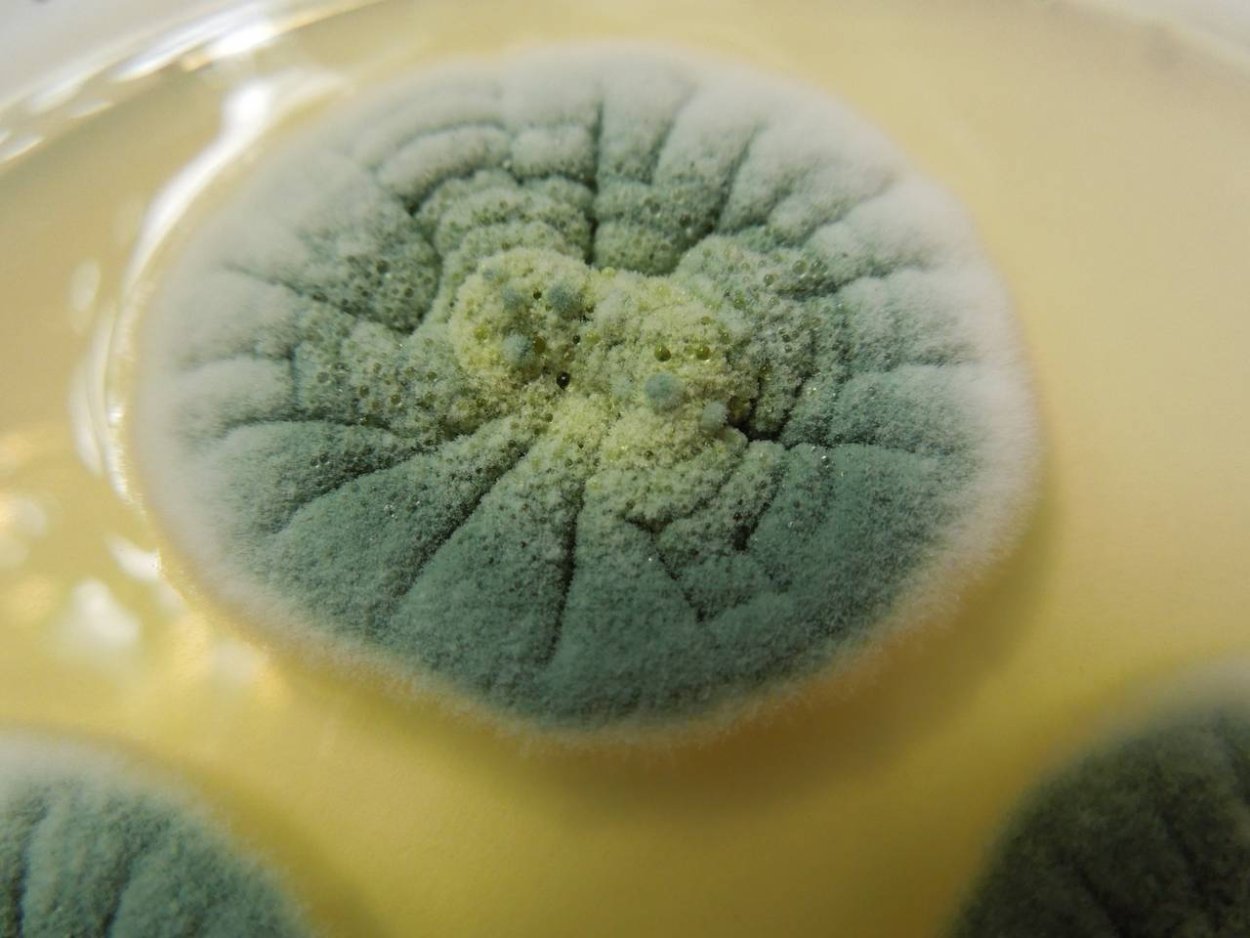
Плесневые грибы пенициллиум
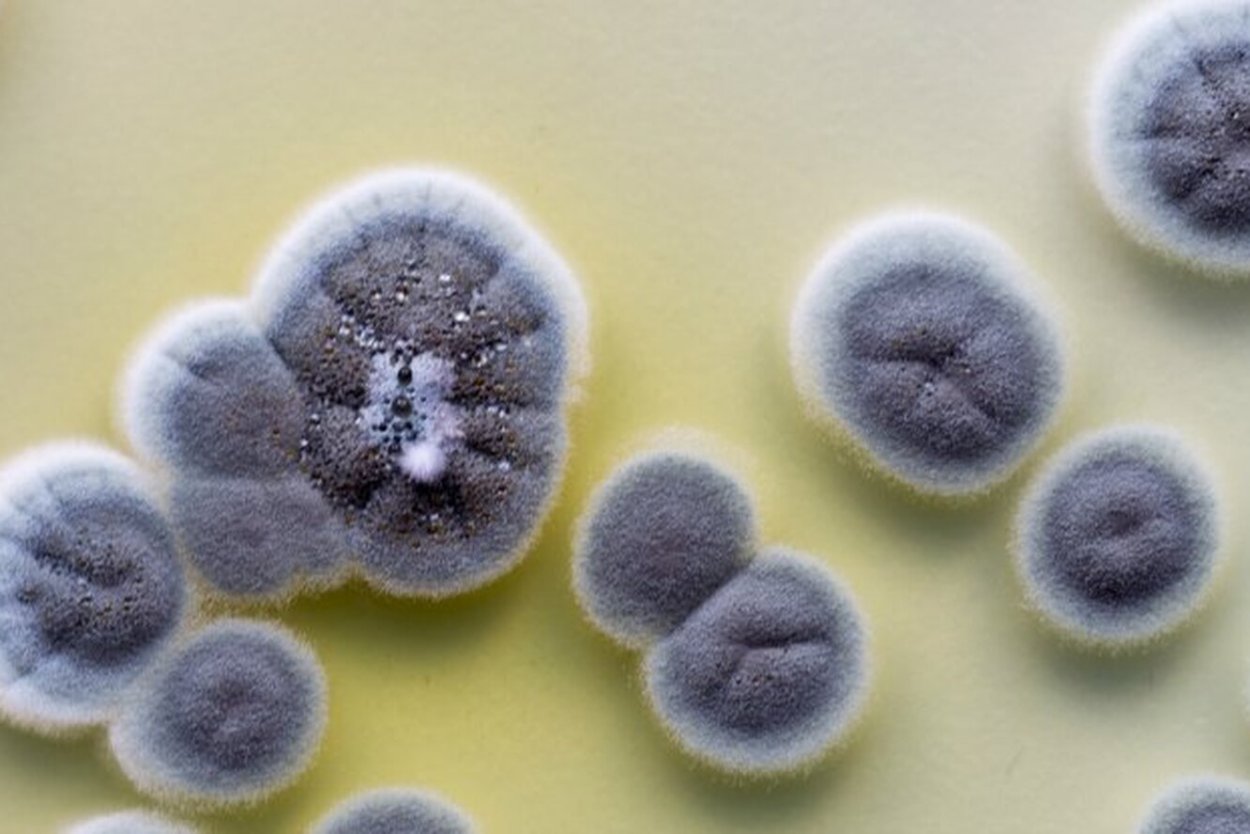
Penicillium citreoviridae
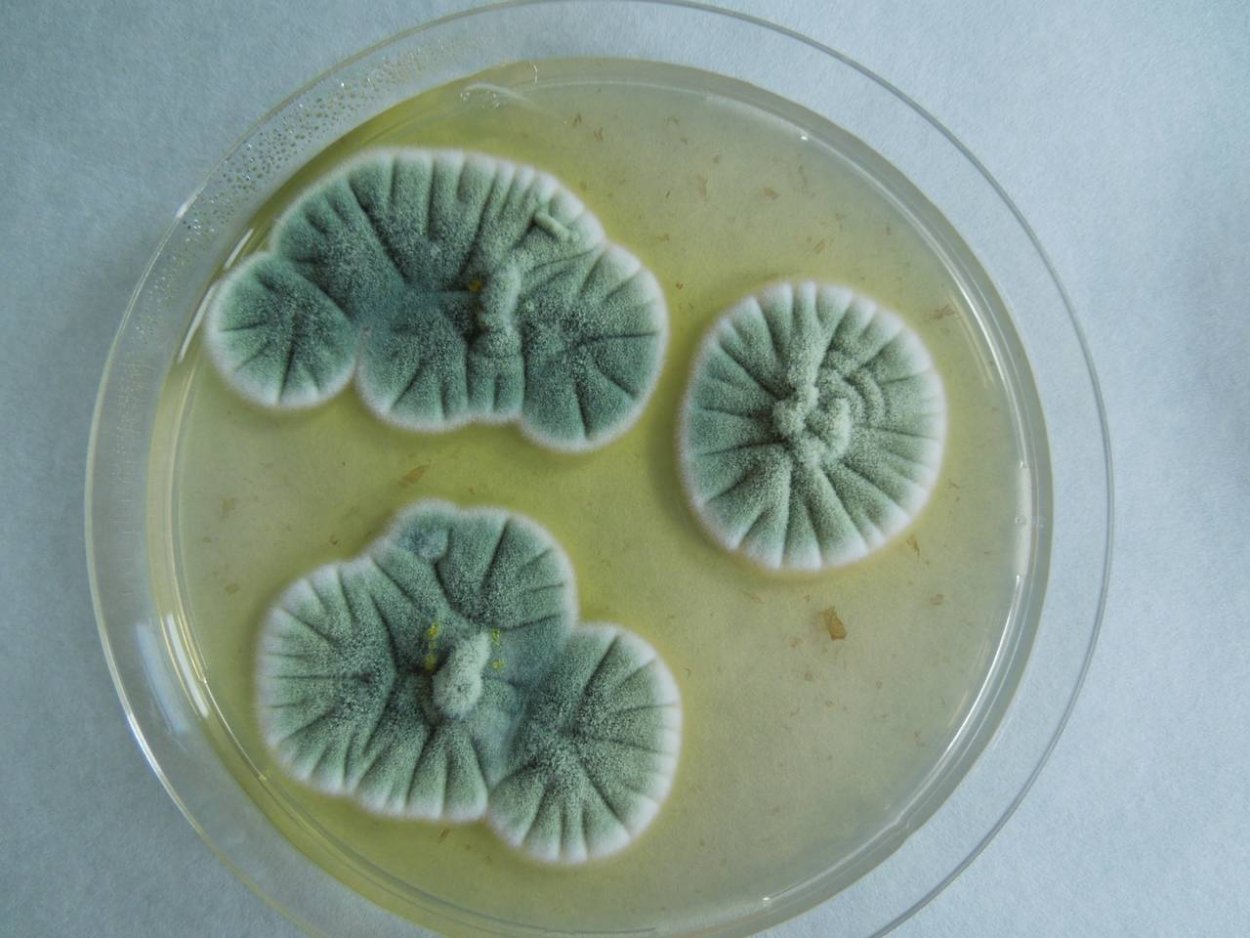
Penicillium notatum-chrysogenum
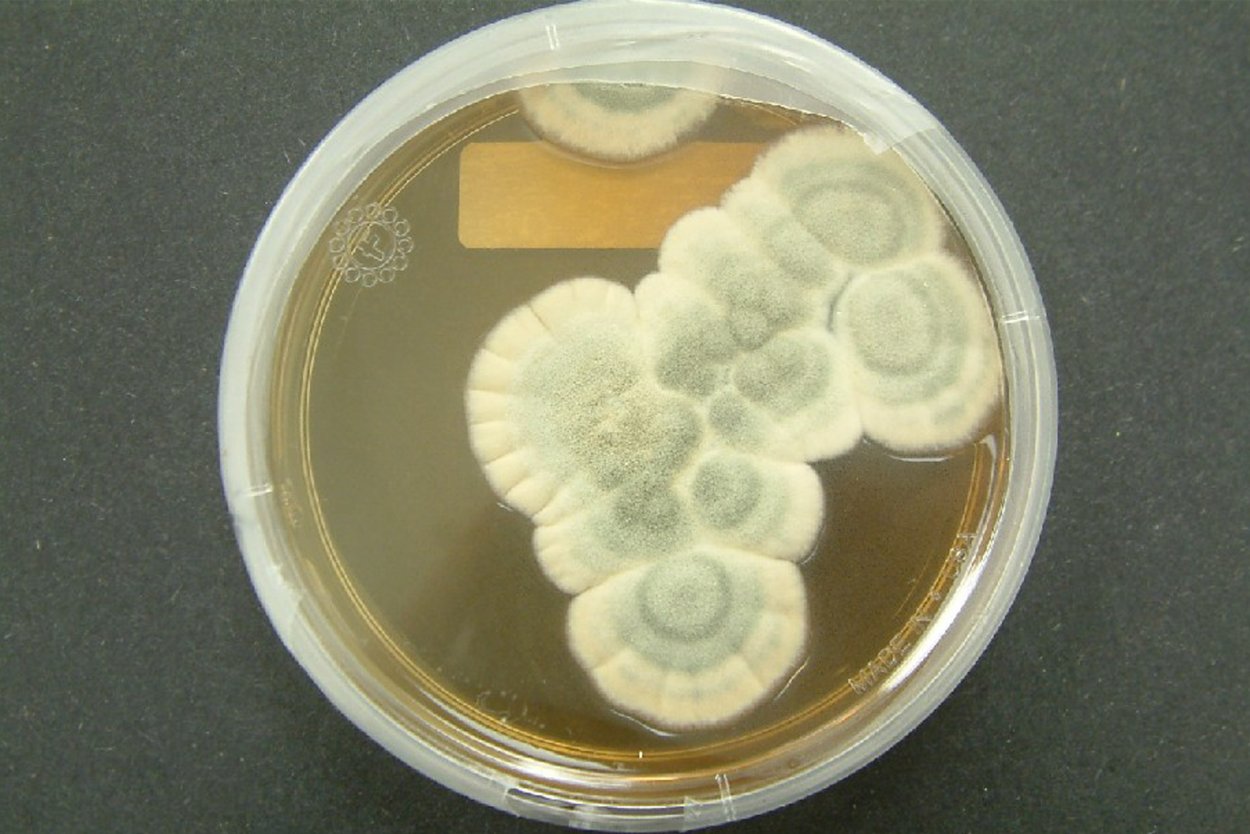
Пеницилл в чашке Петри
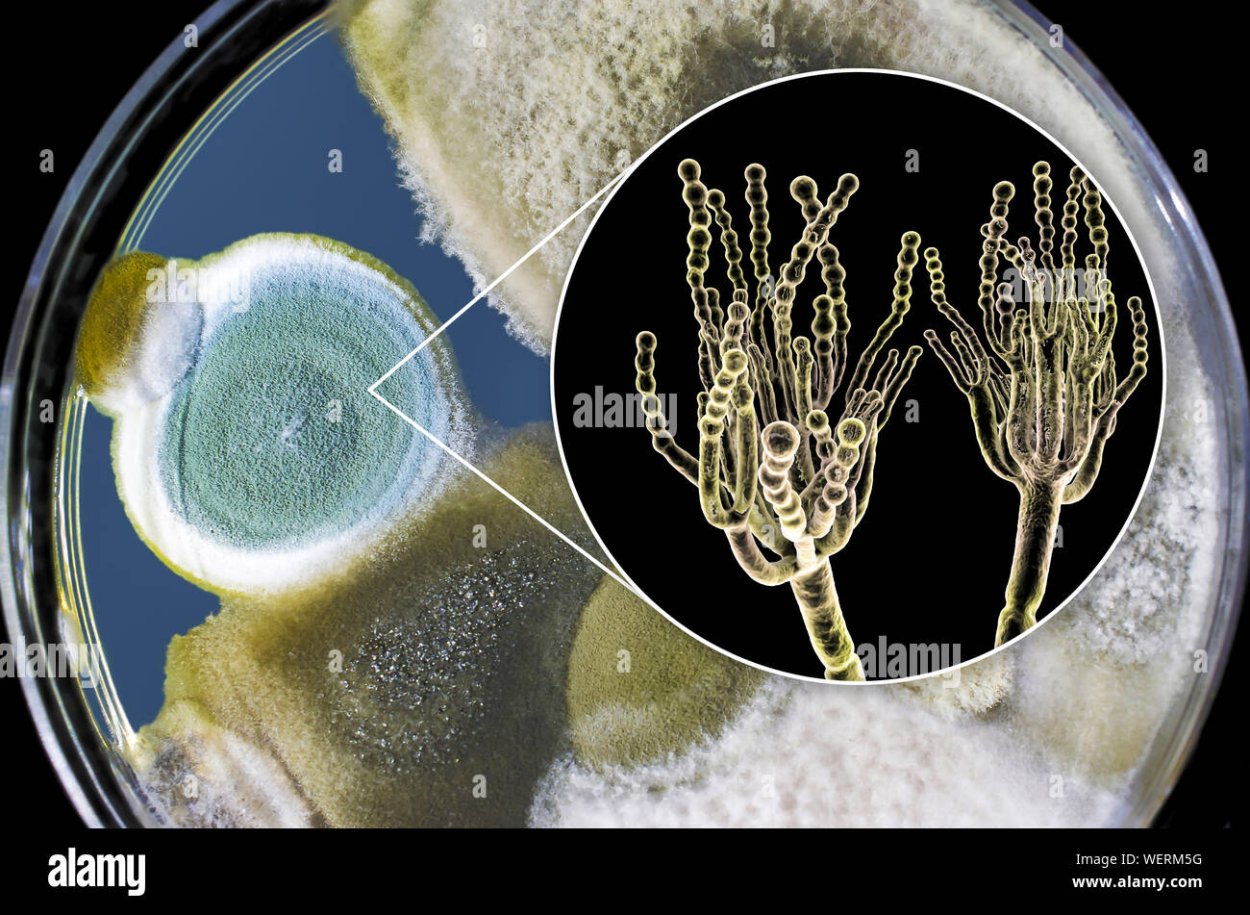
Пенициллиум funiculosum
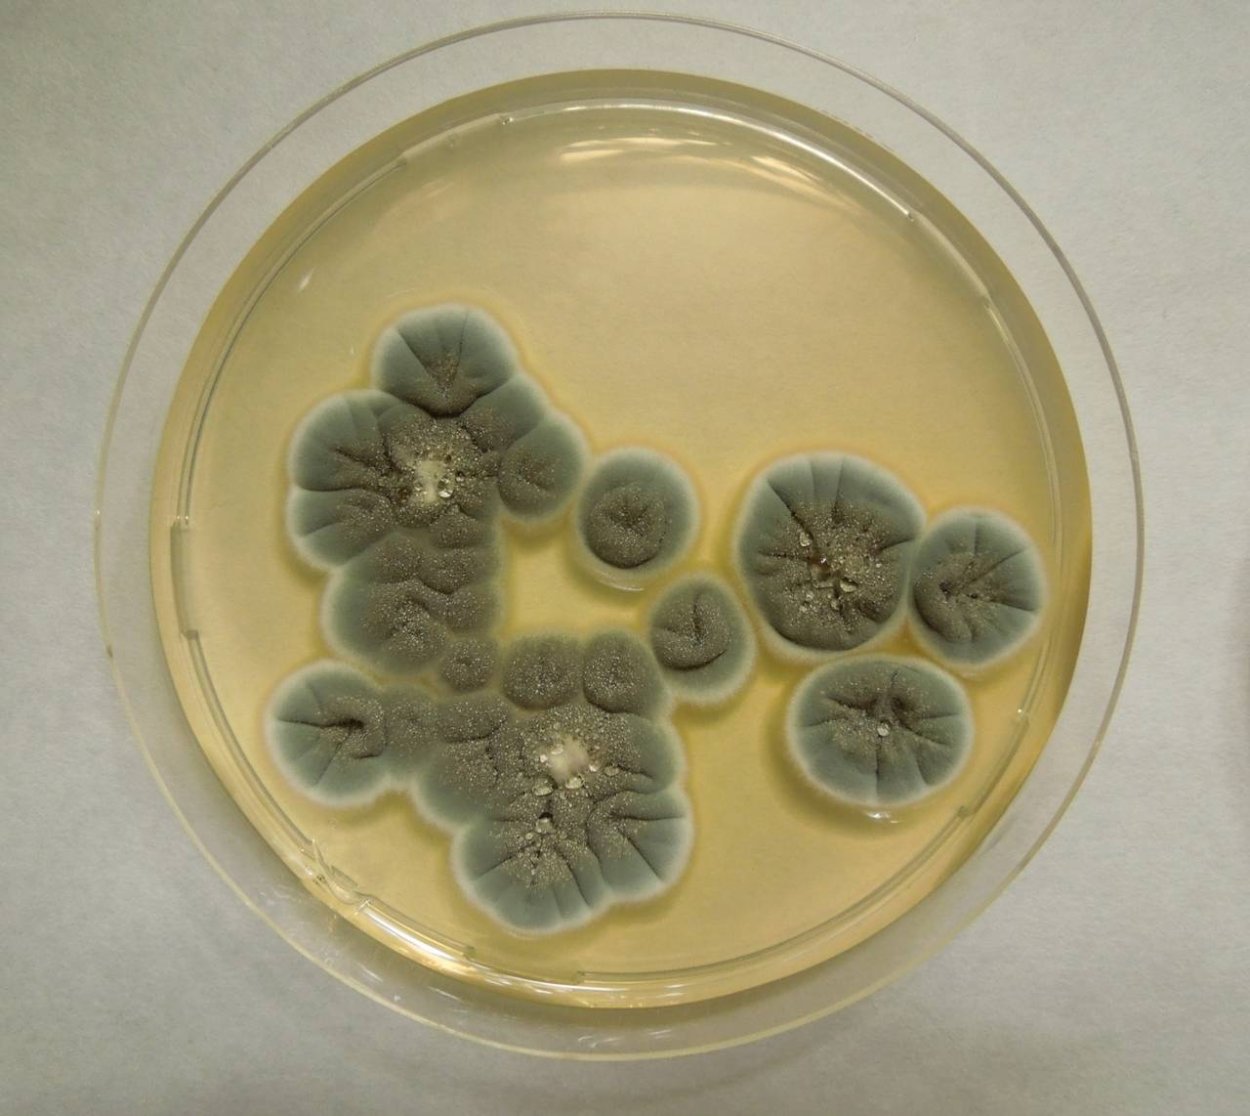
Чашка Петри с плесенью пенициллиум

Пенициллиновые грибы

Пенициллин и мукор
Зеленая плесень пеницилл

Пенициллин (Penicillium)

Конидиеносец пеницилла

Колонии пеницилла

Плесневые грибы пенициллин

Пенициллин notatum

Aspergillus и Penicillium

Плесневые грибы аспергиллус

Пенициллиум гриб

Плесневые грибы пенициллин
Пеницилл в чашке Петри

Penicillium notatum пенициллин

Плесневые грибы в чашке Петри

Микробиология Penicillium Aspergillus

Мицелий Голден Тичер

Пенициллин в чашке Петри

Пенициллин в чашке Петри

Микотоксины плесневых грибов
Микотоксины плесени

Penicillium notatum пенициллин

Плесень пеницилл на хлебе

Ржавчинный гриб паразит

Penicillium notatum пенициллин

Ризопус нигриканс

Фумигатор аспергиллус

Аспергиллус флавус

Penicillium notatum пенициллин

Грибы (микро- и макромицеты)

Плесневые грибы пенициллин
Пенициллин из плесени

Дейтеромицеты пеницилл
Плесневые грибы пенициллиум
Penicillium citreoviridae

Penicillium notatum пенициллин

Гриб Penicillium notatum

Опенок осенний луковичноногий

Плесневые грибы пеницилл

Пенициллин микроскопия


Penicillium spinulosum

Penicillium notatum пенициллин

Пенициллин (Penicillium)

Пенициллин бактерии

Вирусы грибов

Пенициллиум нотатум

Пенициллиум хризогенум

Мицелий пеницилла под микроскопом

Гриб пеницилл и антибиотик

Плесневый гриб пенициллиум

Конидии peronospora

Плесневые грибы аспергиллус
Penicillium notatum-chrysogenum

Гриб пеницилл под микроскопом
Пеницилл в чашке Петри

Плесень Penicillium roqueforti

Пенициллиум нотатум

Гриб слизевик плазмодий
Пенициллиум funiculosum

Грибок растений под микроскопом

Aspergillus restrictus

Пенициллин Эстетика

Пеницилл гриб паразит

Плесень пеницилл микроскоп

Менингококк на чашке Петри

Плесневые грибы грибы аспергилл
Чашка Петри с плесенью пенициллиум

Гриб слизевик плазмодий

Грибы